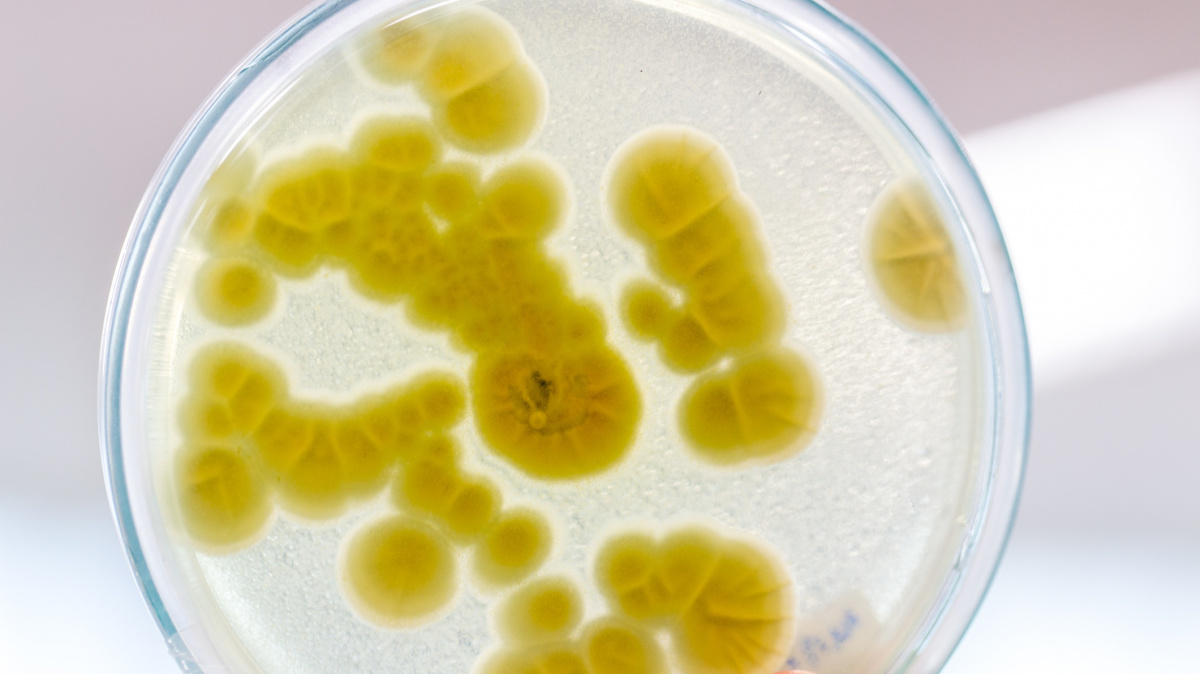

Články autora: Ladislav Loukota
Vesmír
Jsou mimozemšťani uvězněni na svých superplanetách?
5. 5. 2018
|
Ladislav Loukota
Ne všechny planety jsou si rovny. Ačkoliv je k dnešnímu datu známo na 3717 potvrzených exoplanet, tedy planet mimo naší sluneční soustavu, světů s pevným povrchem podobným je mezi nimi minorita. Již několik let vzbuzují zájem tzv. "super-Země", čili možné terestrické světy zřejmě podobné Zemi, ale s větším průměrem, hmotností, a tak i gravitací. Je-li na nich život, prozatím nevíme – pokud by se tam však mimozemšťani skutečně nacházeli, měli by to s únikem ze svých superzemí značně náročné.
Člověk
Archeologové našli důkazy o středověkém masakru. Se zemí srovnal celou vesnici
3. 5. 2018
|
Ladislav Loukota
Bylo to období pádu západořímské říše a Evropa tak byla zmítána chaosem – plundrování a masakry se však odehrávaly nejen v Městě měst, ale i v malé vesničce na pobřeží ostrova Öland na území dnešního Švédska. Tým archeologů tu odkryl důkazy o tom, že kolem roku 450 našeho letopočtu byla většina osady za záhadných důvodů pobita.
Technologie
Vznikl návrh léku na otravu alkoholem. Využívá pokročilých nanokapslí
1. 5. 2018
|
Ladislav Loukota
Na otravu alkoholem ročně zemře ročně odhadem několik stovek tisíc lidí - jen ve Spojených státech je to kolem 88 tisíc. Smrt si překvapivě nevybírá. Vyšším poměrem zemřelých na počet obyvatel disponuje jak Rusko, tak třeba i Francie. Blýská se však na časy - po radě "zaručených" léků proti intoxikaci alkoholem vznikl první návrh skutečného "protijedu" na alkohol. Využívá přitom pokročilých nanotechnologií.
Technologie
Objeveny drahé kovy na stovky let. Jen se k nim nemůžeme dostat
27. 4. 2018
|
Ladislav Loukota
Používáme je v telefonech, počítačích i automobilech – tzv. drahé kovy jsou nezbytnou součástí dnešní elektroniky, a tak i celé moderní civilizace. Svůj název však nemají pro nic za nic. Doposud byla jejich užitná ložiska relativně střídmá a cena se tak pohybovala vysoká. Japonsko však v minulém týdnu odhalilo zásadní objev údajně "skoro nekonečného" naleziště drahých kovů, které by nám mohlo vydržet (při dnešní spotřebě) na celá staletí. Věc má jeden háček: nacházejí se na mořském dně.
Člověk
Nové genové terapie začaly léčit dědičné nemoci krve. Vyléčily už první pacienty
25. 4. 2018
|
Ladislav Loukota
Nikoliv jeden, ale hned tři různé projekty se v dubnu vytasily s genovou terapií, která mohla léčit pacienty se souborem dědičných nemocí krve jménem talasémie. Většina terapií vyvinutá mezinárodním týmy zatím čeká na schválení pro klinické testy, první z pokusů na lidech však již zbavil choroby 22 pacientů ve Spojených státech. A blíží se i nezávislé testy na evropské půdě.
Vesmír
Sluneční soustava měla o planetu víc, naznačuje meteorický diamant
24. 4. 2018
|
Ladislav Loukota
Mladá sluneční soustava byla extrémně chaotickým místem. Trvalo miliony let, než se náš současný domov dostal do stavu relativní stability, jaký si posledních několik miliard let užívá – a který umožnil i bezpečný vývoj mnohobuněčného života na Zemi. Nová práce vědců ze Švýcarska, Francie a Německa nám dává zcela nový náhled na to, jak moc byla tato perioda mládí sluneční soustavy brutální. Zdá se totiž, že minimálně jedna (spíše více) planet první generace byla zcela zničena.
Technologie
Novou podvodní GPS inspirovaly oči garnátů, pomůže ponorkám
19. 4. 2018
|
Ladislav Loukota
Tmavě modré prostředí pod vodní hladinou nedává lidem mnoho možných metod navigace a povrchové aparáty jako GPS pod mořem také selhávají. Queenslandská univerzita ovšem pomocí svého nového vynálezu možnosti podvodní navigace mění – podařilo se jí vyvinout senzor, který může až do několika stovek metrů přesně určit pozici plavidla. Inspirací pro něj byla zraková ústrojí hlubokomořských živočichů.
Technologie
Nově objevená antibiotika si poradí se strašákem rezistence
15. 4. 2018
|
Ladislav Loukota
Antibiotická rezistence je velkým strašákem moderní medicíny. Hrozí totiž, že jedny z nejvýznamnějších léčiv se v dohledné době stanou proti řadě nemocí neúčinné. Spojenému americko-francouzskému týmu se ovšem možná podařilo objevit a popsat zcela novou třídu antibiotik, které proti patogenům zasahují způsobem, proti němuž nemají rezistentní bakterie prozatím obranu.